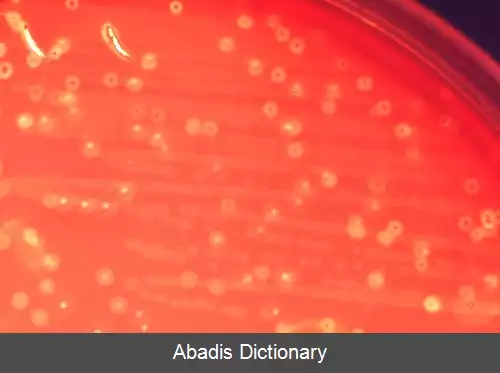
عکس استرپتوکوک آنژینوسوس

استرپتوکوک آنژینوسوس. استرپتوکوک آنژینوسوس ( Streptococcus anginosus ) ، گونه ای از استرپتوکوک است. این باکتری به همراه استرپتوکوک کانستلاتوس و استرپتوکوک اینترمدیوس، گروه آنژینوسوس را تشکیل می دهند[ ۱] گاهی اوقات به آن، گروه میلری ( milleri group ) نیز می گویند. ارتباط فیلوژنتیکی این گونه ها با استفاده از آنالیز توالی rRNA به تأیید رسیده است[ ۲]
بیشتر سویه های استرپتوکوک آنژینوسوس، از گلوکز، استوئین را تولید می کنند. آن ها لاکتوز، ترهالوز، سالیسین و سوکروز را تخمیر می کنند و آرژنین و اسکولین را هیدرولیز می نمایند. دی اکسید کربن رشد باکتری را افزایش می دهد. این باکتری ممکن است بتا همولیتیک یا غیر همولیتیک باشد. برخی نیز ممکن است آلفا همولیتیک باشند. [ ۳]
این باکتری، بخشی از میکروفلور انسان است اما گاهی اوقات می تواند بیماریزا باشد مانند آبسه های کبدی و مغزی. باکتری از مناطق گوناگون بدن مانند دهان، گلو، مدفوع و واژن جدا شده است. [ ۳]
بیشتر سویه ها به باسیتراسین، نیتروفورانتوئین و سولفونامیدها مقاوم هستند. [ ۴] بیشتر سویه ها به پنی سیلین، آمپی سیلین، اریترومایسین و تتراسایکیلین حساس می باشند. [ ۵]
این نوشته برگرفته از سایت ویکی پدیا می باشد، اگر نادرست یا توهین آمیز است، لطفا گزارش دهید: گزارش تخلفبیشتر سویه های استرپتوکوک آنژینوسوس، از گلوکز، استوئین را تولید می کنند. آن ها لاکتوز، ترهالوز، سالیسین و سوکروز را تخمیر می کنند و آرژنین و اسکولین را هیدرولیز می نمایند. دی اکسید کربن رشد باکتری را افزایش می دهد. این باکتری ممکن است بتا همولیتیک یا غیر همولیتیک باشد. برخی نیز ممکن است آلفا همولیتیک باشند. [ ۳]
این باکتری، بخشی از میکروفلور انسان است اما گاهی اوقات می تواند بیماریزا باشد مانند آبسه های کبدی و مغزی. باکتری از مناطق گوناگون بدن مانند دهان، گلو، مدفوع و واژن جدا شده است. [ ۳]
بیشتر سویه ها به باسیتراسین، نیتروفورانتوئین و سولفونامیدها مقاوم هستند. [ ۴] بیشتر سویه ها به پنی سیلین، آمپی سیلین، اریترومایسین و تتراسایکیلین حساس می باشند. [ ۵]
wiki: استرپتوکوک آنژینوسوس
